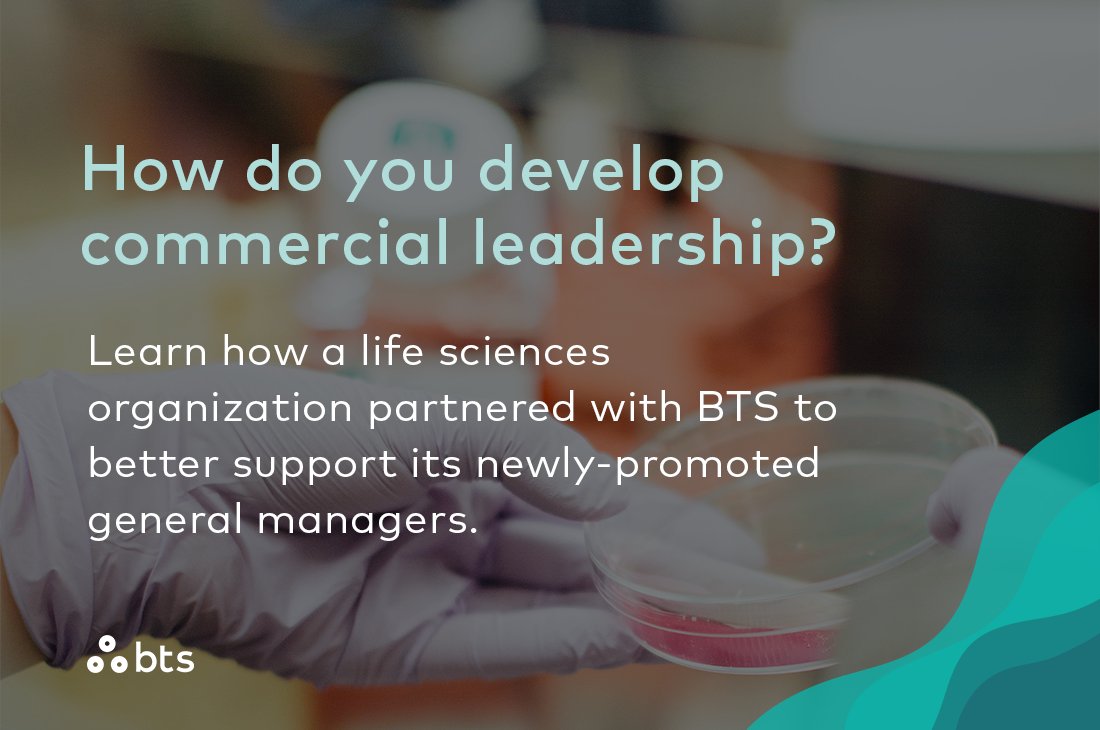
How do you develop commercial leadership? Learn how a life sciences organization partnered with BTS to better support its newly-promoted general managers: bit.ly/3KZPiFW #StrategyMadePersonal #sales #leadership #development

BTS
@btsgroupab
BTS, the global leader in accelerating strategy implementation, innovates how organizations change, learn and improve for better business results.
ID: 36115971
http://www.bts.com 28-04-2009 16:54:00
2,2K Tweet
2,2K Followers
635 Following